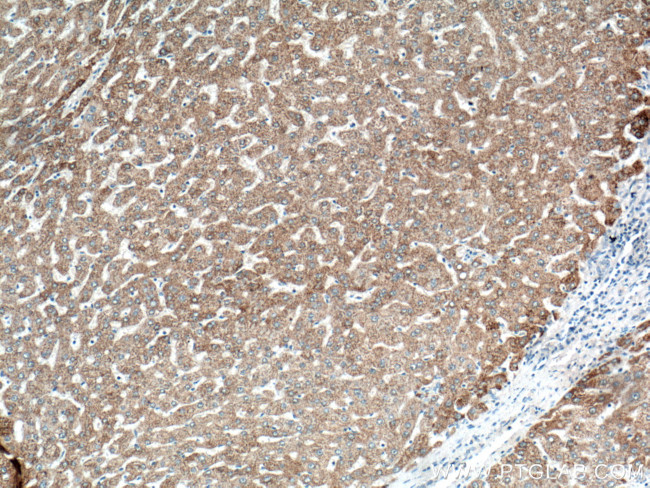
OTC Antibody in Immunohistochemistry (Paraffin) (IHC (P))

Search
Proteintech
OTC Polyclonal Antibody
{{$productOrderCtrl.translations['antibody.pdp.commerceCard.promotion.promotions']}}
{{$productOrderCtrl.translations['antibody.pdp.commerceCard.promotion.viewpromo']}}
{{$productOrderCtrl.translations['antibody.pdp.commerceCard.promotion.promocode']}}: {{promo.promoCode}} {{promo.promoTitle}} {{promo.promoDescription}}. {{$productOrderCtrl.translations['antibody.pdp.commerceCard.promotion.learnmore']}}
产品信息
26470-1-AP
种属反应
宿主/亚型
分类
类型
抗原
偶联物
形式
浓度
规格
纯化类型
保存液
内含物
保存条件
运输条件
产品详细信息
Immunogen sequence: VQLKGRDLL TLKNFTGEEI KYMLWLSADL KFRIKQKGEY LPLLQGKSLG MIFEKRSTRT RLSTETGFAL LGGHPCFLTT QDIHLGVNES LTDTARVLSS MADAVLARVY KQSDLDTLAK EASIPIINGL SDLYHPIQIL ADYLTLQEHY SSLKGLTLSW IGDGNNILHS IMMSAAKFGM HLQAATPKGY EPDASVTKLA EQYAKENGTK LLLTNDPLEA AHGGNVLITD TWISMGQEEE KKKRLQAFQG YQVTMKTAKV AASDWTFLHC LPRKPEEVDD EVFYSPRSLV FPEAENRKWT IMAVMVSLLT DYSPQLQKPK F (35-354 aa encoded by BC074745)
靶标信息
This nuclear gene encodes a mitochondrial matrix enzyme. Missense, nonsense, and frameshift mutations in this enzyme lead to ornithine transcarbamylase deficiency, which causes hyperammonemia. Since the gene for this enzyme maps close to that for Duchenne muscular dystrophy, it may play a role in that disease also.
仅用于科研。不用于诊断过程。未经明确授权不得转售。
生物信息学
蛋白别名: Ornithine carbamoyltransferase, mitochondrial; ornithine transcarbamylase; Ornithine transcarbamylase, mitochondrial; OTCase; sparse fur; unnamed protein product
基因别名: AI265390; OCTD; OTC; OTC1; OTCase; OTCD; Sf; spf
UniProt ID: (Human) P00480, (Mouse) P11725, (Rat) P00481
Entrez Gene ID: (Human) 5009, (Mouse) 18416, (Rat) 25611